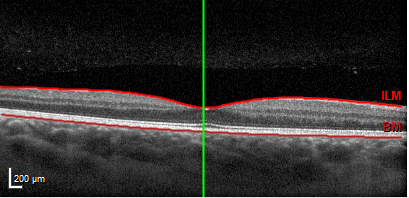

L'OCT, qu'est-ce-que c'est ?
L’OCT ou tomographie en cohérence optique est une technique d’imagerie très performante, rapide et indolore, qui permet de réaliser des images en coupes multiples de la rétine avec une résolution de quelques microns.

L’OCT ou tomographie en cohérence optique est une technique d’imagerie très performante, rapide et indolore, qui permet de réaliser des images en coupes multiples de la rétine avec une résolution de quelques microns. Cet examen est devenu indispensable en consultation rétine et permet de confirmer un diagnostic avec précision comme un trou maculaire, une membrane épi-maculaire, une DMLA exsudative, un œdème maculaire, etc. ... Il permet par ailleurs d’évaluer l’efficacité d’un traitement en réalisant des clichés comparatifs à chaque consultation. Cet examen ne nécessite aucune préparation et notamment pas de dilatation des pupilles.
Coupe OCT d'une macula saine :
Un nouvel OCT appelé OCT-angio permet d’identifier les flux dans les vaisseaux rétiniens et choroïdiens sans injection de produit de contraste. Il peut dans certaines circonstances être d’un précieux intérêt pour préciser par exemple la présence ou non d’un vaisseau anormal et ainsi permettre de s’affranchir d’une angiographie.